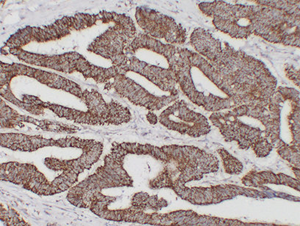
01 GB14098 HSP60 H colon carcinoma d200_IHC.png

Anti-Hsp60 Mouse mAb
- 50 μL
Product Information
Protein full name | 60 kDa heat shock protein, mitochondrial (60 kDa chaperonin) (Chaperonin 60) (CPN60) (Heat shock protein 60) (HSP-60) (Hsp60) (HuCHA60) (Mitochondrial matrix protein P1) (P60 lymphocyte protein) |
Gene Id | 3329 |
Immunogen | Synthesized peptide derived from Human Hsp60 |
Uniprot ID | P10809 |
Source | Mouse/IgG1, Kappa |
Concentration | 1 mg/ml |
Purity | The antibody was affinity-purified from mouse ascites by affinity-chromatography using specific immunogen. |
Applications
IHC/IF | Human | 1: 200-1: 500 | colon carcinoma |
Background
heat shock protein family D (Hsp60) member 1(HSPD1) Homo sapiens This gene encodes a member of the chaperonin family. The encoded mitochondrial protein may function as a signaling molecule in the innate immune system. This protein is essential for the folding and assembly of newly imported proteins in the mitochondria. This gene is adjacent to a related family member and the region between the 2 genes functions as a bidirectional promoter. Several pseudogenes have been associated with this gene. Two transcript variants encoding the same protein have been identified for this gene. Mutations associated with this gene cause autosomal recessive spastic paraplegia 13. [provided by RefSeq, Jun 2010],
Images
| Immunohistochemistry analysis of paraffin embedded human colon carcinoma using Hsp60 (GB14098) at dilution of 1: 200 |
Storage
| Storage | Store at -20 ℃ for one year. Avoid repeated freeze/thaw cycles. |
| Storage Buffer | Liquid in PBS containing 50% glycerol, 0.5% BSA and 0.02% sodium azide. |
NOTE:
1.This product is intended for research only.
2.This product is recommended to dilute with the Primary Antibody Dilution Buffer (G2025).
| 货号 | 名称 | 规格 | 价格 | 操作 |
|---|
| 货号 | 名称 | 规格 | 价格 | 操作 |
|---|